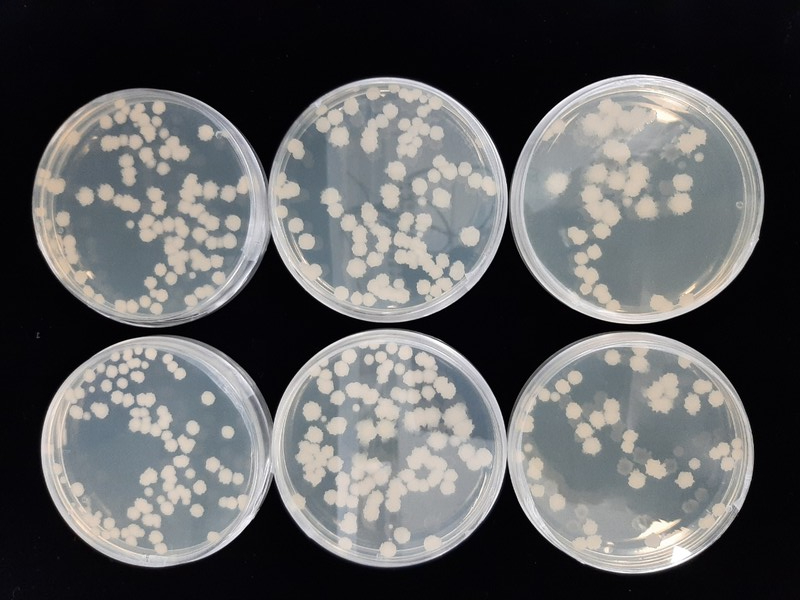

- 혈전용해 활성 87.9%...전통 발효미생물이 검증된 기능성 소재로 지역기업에 통상실시 기술이전
- 청국장 제조 적합성·기능성 성분 풍부...토종 균주 연구 2019년 착수 이래 성과의 연속, 치매 예방 후보군까지 선발 중
[한국지방정부신문=이상금 기자] 충남도 농업기술원이 자체 선발·육성한 토종 고초균(청국장균) BC160CK48의 기술이전 사실은 단순한 학술 성과를 넘어 지역 발효식품의 부가가치 창출과 건강기능성 식품 산업화의 출발점이라는 점에서 의의가 크다.
이번 충남 농업기술원의 기술이전은 ‘연구 → 균주 확보 → 기술이전 → 산업화’로 이어지는 지역 혁신의 전형을 보여준다.
이번 균주는 시험관(인 vitro) 수준에서 혈액 속의 혈전을 분해하는 ‘혈전용해 활성’이 87.9%로 보고됐고, 충남도는 해당 균주와 청국장 제조기술을 당진 소재 온헬쓰바이오(주)에 통상실시 방식으로 이전해 상용화를 추진한다
해외·국내의 여러 학술검토와 임상 전·임상 연구는 낫토키나제(nattokinase) 등 발효미생물이 생산하는 혈전용해 효소가 시험관 내·동물실험에서 강한 섬유소 분해능을 보이며 심혈관계 질환의 예방·보조적 관리에서 잠재력이 크다고 결론짓는다.
특히 단일 복용으로도 혈전 분해를 촉진했다는 연구 결과들이 있어 ‘경구 투여가 가능한 단백질계 혈전용해 보조소재’로서의 관심이 높다.
이 같은 국제적 근거는 충남 농기원이 선발한 토종 고초균의 혈전용해 활성 표기가 단순 홍보 문구가 아니라 기능성 소재로서 충분히 검토될 만한 배경을 제공한다.
시험관·동물 수준과 사람 대상 효과는 차이가 있으므로 상용화 과정에서 안전성과 유효성 입증(임상시험 등)이 병행되어야 한다는 점도 학계는 지적한다.
보고서와 기술이전 공지에 따르면 BC160CK48은 청국장 제조 시 점질물(점착성 물질) 생성력이 좋아 전통식의 특징을 유지하면서도 아미노태 질소와 폴리페놀 등 기능성 성분이 풍부하게 형성되는 것으로 확인됐다.
이는 단순히 ‘혈전용해 효소 생산균’ 이상의 가공적·감각적 장점을 뜻한다. 즉, 식품제조업체는 이 균주를 활용해 청국장 등 전통 장류의 제품특성을 살리면서도 기능성을 전면에 내세운 제품 라인을 개발할 수 있다.
충남농기원은 2019년부터 토종 식품균주의 기능성 규명과 선발 연구를 지속해 왔으며, 이번 성과는 그 연장선상에 있다.
충남농업기술원의 이종국 농식품자원팀장은 토종 균주 개발과 발효 식품 소재의 중요성을 강조하며 도내 농식품 산업 경쟁력 제고에 기여하겠다는 의지를 전했다.
한편, 외부 전문가(학계)의 관점에서 이번 기술이전의 가치는 세 가지 축으로 요약된다.
첫째, 지역 연구기관의 균주 확보와 기술이전은 중소·중견 가공업체가 제품 고유성을 확보할 기회를 준다.
둘째, ‘혈전용해 활성 87.9%’라는 수치는 실험실 지표로서 유망하지만, 제품화 시에는 균주 배양·발효조건·제조공정에 따른 효소 활성의 변동성, 식품·건강기능식품으로서의 안전성(예: 독성·면역반응) 검증, 그리고 규격(활성 단위 등)·표준화 이슈를 먼저 해결해야 한다는 점이다.
셋째, 상용화를 준비하는 기업은 식품의약품안전처 등 관련 규제기관의 기능성 표시·건강기능식품 인정 절차를 검토하며 임상적 근거 축적을 병행하는 것이 바람직하다.
이러한 전문적 평가들은 국내외의 나토키나제 관련 학술 리뷰와 임상·전임상 연구에서 제기되는 권고사항과도 맥을 같이한다.
충남도 농업기술원이 강조하는 ‘토종 식품균주’ 전략은 추가적 부가가치 창출과 지역 브랜드화라는 목표를 지닌다.
최근 몇 년간 국내 연구들은 청국장·낫토 등 전통 발효식품에서 유래한 균주들이 낫토키나제류의 효소를 포함해 혈류 개선, 항혈소판, 항염 등 다양한 생리활성을 낼 수 있음을 보고해 왔다.
충남농기원은 2019년부터 시작한 균주 선발·평가 사업에서 미백 효과 효모(특허출원 10-2023-0024516호), 항관절염 활성 효모 등 여러 기능성 균주를 연이어 개발했고, 현재는 치매 예방 효과가 높은 토종 균주 선발 연구까지 추진하고 있다. 이러한 연속성은 단발성 연구 성과가 아니라 전략적 R&D 투자의 결과물로 읽힌다.
기술이전을 받은 온헬쓰바이오(주)는 이번 균주를 바탕으로 건강식품 상용화를 계획하고 있다. 지역 소재 기업이 공정 기술과 균주를 확보하면 제품 출시를 통해 지역 고용·부가가치가 창출될 가능성이 크다.
특히 전통 발효식품은 ‘로컬리티(지역성)’와 ‘전통성’이라는 마케팅 강점을 갖고 있어, 기능성을 더한 제품은 프리미엄 시장에서 경쟁력을 확보할 수 있다.
시장 진입 초기에는 소비자 안전성 확보와 적절한 라벨링, 과학적 근거 제시가 소비자 신뢰 형성의 관건이 될 것이다.

